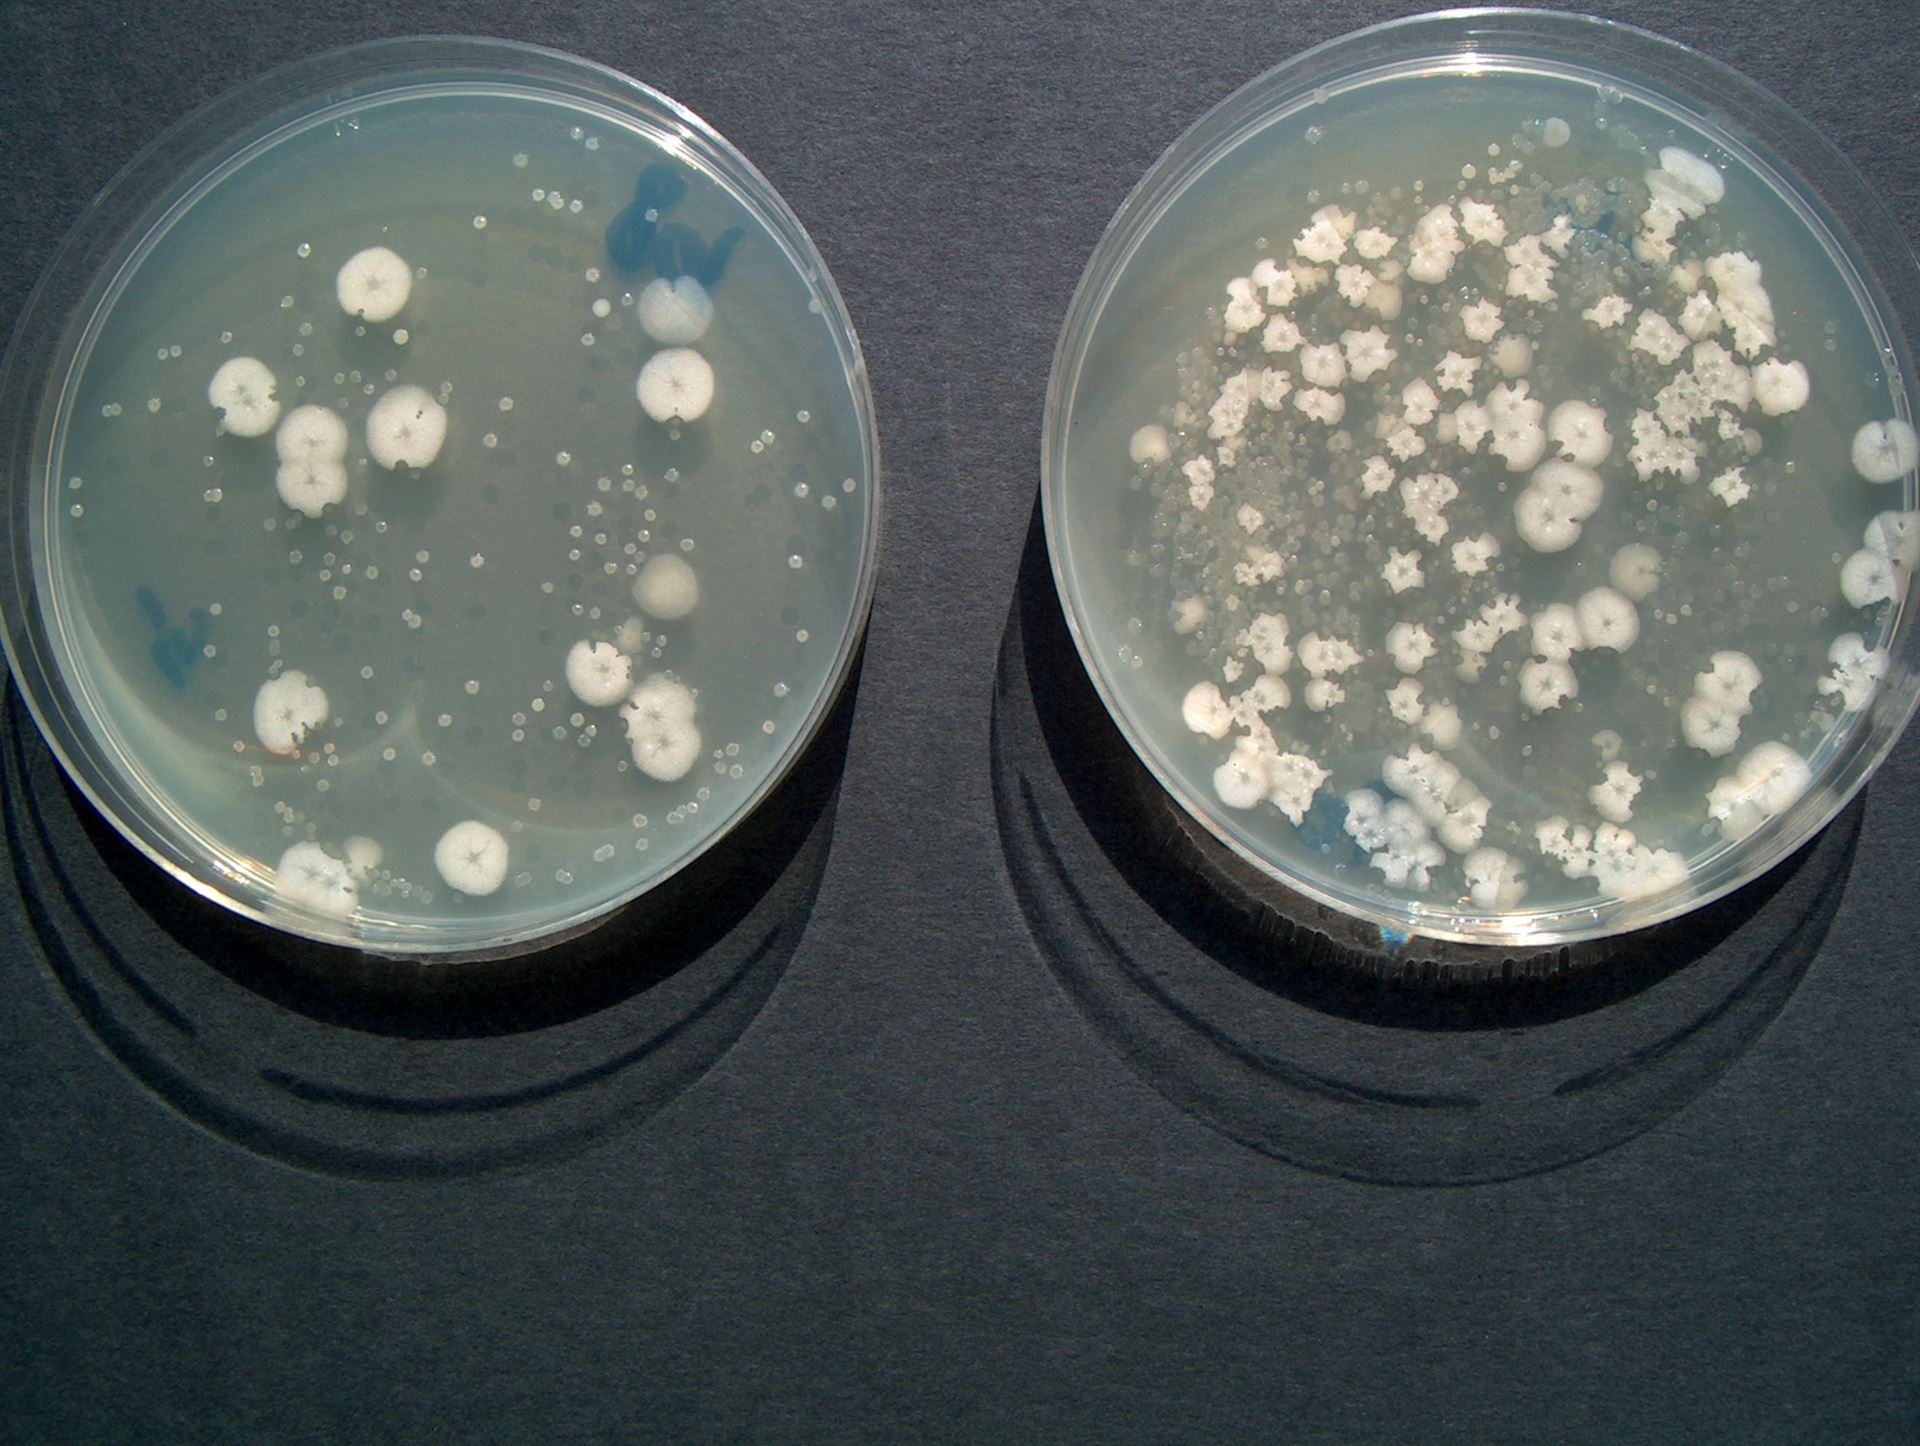
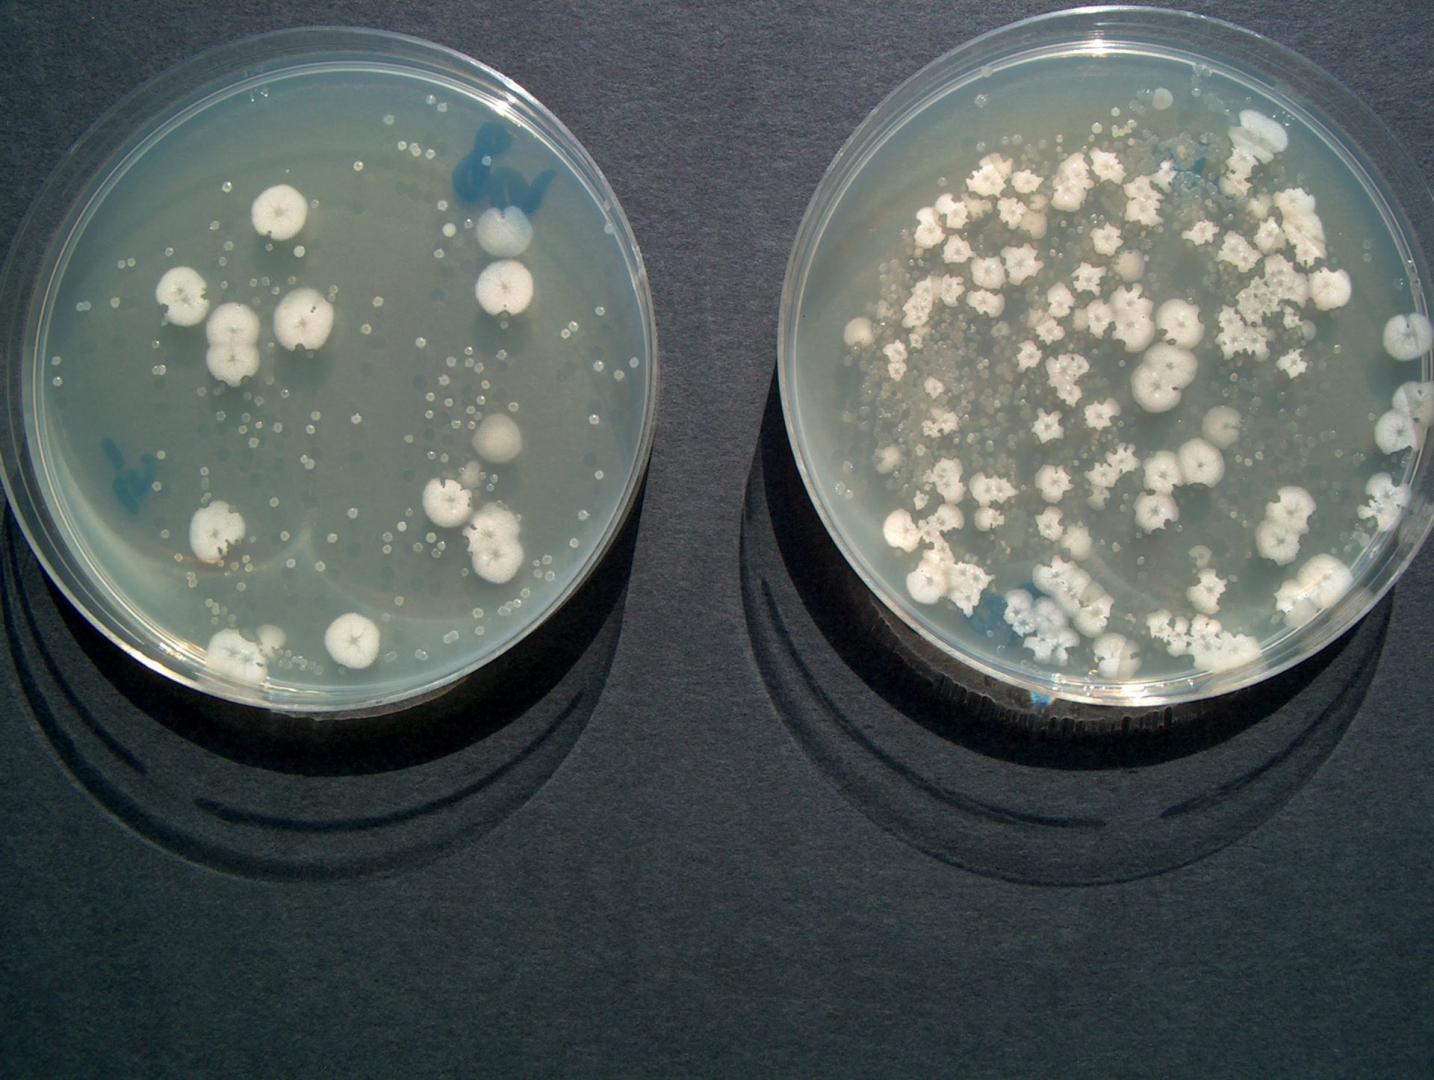

CASIBAC
Unsere Produkte und Lösungen tragen den Namen CASIBAC. Sie sind 100% biologisch und sehr wirksam.
CASIBAC Produkte enthalten natürliche Bakterien aus unsere normalen Umwelt. Sie sind für Mensch, Tier und Umwelt harmlos und nicht schädlich. CASIBAC Bakterien sind sogar essbar (Achtung dies ist keine Verzehrempfehlung).
Zig-Millionen von Bakterien

Die CASIBAC Produkte bestehen aus Millionen kleinster Helfer. Es sind Bakterien, die durch ihren Stoffwechsel (Metabolismus) organische Abfallstoffe verdauen. Diesen Vorgang nennt man biologisch abbauen.
Der biologische Abbau ist ein wichtiger Teil des natürlichen Stoffkreislaufs (biologisches Recycling) auf unserer Erde. Abfallstoffe werden von Bakterien in ihre chemischen Bestandteile abgebaut. Diese Grundstoffe können dadurch von Pflanzen und Bäumen wieder aufgenommen werden.
So werden die organischen Stoffe wieder verwertet, Pflanzen und Bäume wachsen und gedeihen.
Bei den kleinen Helfern handelt es sich um natürliche Bodenbakterien, die überall in der Natur vorkommen. Sie sind vor allem im Boden zu finden, aber auch im Wasser und sogar in staubiger Luft. Sie sind für Mensch, Tier und Umwelt harmlos und nicht schädlich. Sie werden durch moderne wissenschaftliche Methoden ausgesucht, kultiviert und für den praktischen Einsatz haltbar gemacht.
Das Bild zeigt CASIBAC Bakterien 10'000x vergrössert.
Aus dem Biologiebuch
Bakterien sind einzellige Lebewesen. Sie sind mikroskopisch klein, nur etwa 1-2 Tausendstel Millimeter gross. Nach Schätzungen gibt es bis zu drei Millionen verschiedene Arten, und sie erfüllen auf unserer Welt die vielfältigsten Aufgaben.
So dienen z.B. Milchsäurebakterien zur Herstellung von Yoghurt und Bifidus. Besonders ausgesuchte Bakterienstämme wie LC1 tragen zu unserem Wohlbefinden bei. Auch Wein und Bier entstehen durch biologische Gärprozesse.
Grünabfälle werden mit Hilfe von Bodenbakterien kompostiert, spezielle Bakterien produzieren Biogas daraus. Auch die biologische Abwasserreinigung in der Kläranlage ist das Werk zahlreicher Bakterien.
Bild: Schema einer Bakterienzelle
Kleines Glossar
Biologischer Abbau
Der biologische Abbau von Abfallstoffen ist Teil des natürlichen Stoffkreislaufes in der Natur. Der biologische Abbau wird von Bakterien durch ihren Stoffwechsel vorgenommen. Im Gegensatz dazu tragen Enzyme nicht direkt zum biologischen Abbau bei, da sie Stoffe nur aufteilen.
Enzyme, freie Enzyme
Enzyme sind Katalysatoren in biochemischen Reaktionen, sie sind auch als Fermente bekannt. Es sind „Spalt-Stoffe“, welche komplizierte Moleküle in zwei (oder mehrere) Teile spalten:
AB ---> A + B
Enzyme werden von Bakterien gebildet, um komplexe Moleküle für den Stoffwechsel verfügbar zu machen. Enzyme sind nicht sehr stabil und werden von den Bakterien wieder abgebaut.
Freie Enzyme sind aus Bakterienkulturen gewonnene, isolierte und stabilisierte Enzyme. Sie werden grosstechnisch hergestellt und in verschiedensten Bereichen eingesetzt. Fast jedes Haushalt-Waschmittel enthält freie Enzyme.
Mikroorganismen
Mikroorganismen oder Bakterien sind einzellige Organismen mit eigenem Stoffwechsel (= biologische Aktivität). Durch den Stoffwechsel (Metabolismus) werden Stoffe z.B. mit Hilfe von Sauerstoff (O2) verbrannt (oxydiert). Die daraus gewonnene Energie dient zum Unterhalt und zum Wachstum des Organismus (Vermehrung der Bakterien). Stoffwechsel Abfallprodukt ist z.B. CO2 (Atemluft) und H2O (Wasser):
A ----> Energie + CO2 + H2O
Der Stoffwechsel und die Aktivität der Bakterien erzeugen einen messbaren Sauerstoffverbrauch. In der Abwasserreinigung sind z.B. die momentane Sauerstoffzehrung und der Sauerstoff-verbrauch während 5 Tagen (BSB5) wichtige Messgrössen.
Umweltfreundlicher und günstiger Einsatz
CASIBAC ist vollständig biologisch abbaubar. Es ist nicht giftig, enthältkeine umweltbelastenden Stoffe und hinterlässt keine Rückstände.
Die Behandlung der organischen Abfälle mit CASIBAC ist oft effizienter und kostengünstiger als der Einsatz herkömmlicher chemischer Produkte. Diese überdecken oder verschieben das Abfallproblem nur (Symptombekämpfung); denn chemische Produkte müssen ihrerseits wieder abgebaut werden und belasten die Umwelt.
Das Bild zeigt CASIBAC Bakterien auf Nährschalen.